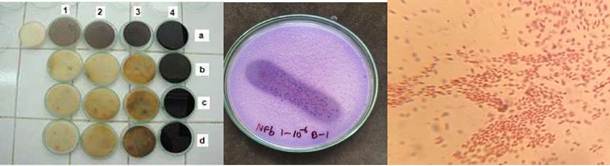

Esta sección de Ecología en Bolivia, se divulga a nivel institucional y comunica sobre anuncios de cursos, congresos y conferencias (que se vayan a realizar o que se hayan realizado recientemente), oferta de becas, declaraciones de eventos internacionales, financiamiento de proyectos, anuncios de empleos, proyectos en realización y otro tipo de noticias y eventos importantes para biólogos y ecólogos bolivianos, así como de la región.
Introducción
A los “50 Años del aniversario de la Carrera de Biología (21 septiembre 1972-2022), presentamos este “Resumen histórico y producción intelectual” en homenaje por los hitos históricos que ha reflejado el crecimiento y despliegue de la Carrera de Biología de la Facultad de Ciencias Puras y Naturales (FCPN) de la Universidad Mayor de San Andrés (UMSA) desde 1972. La información ha sido recabada de documentos y publicaciones para reunir la cronología y los avances logrados que han acompañado estos 50 años: Como el publicado por Morales (2008) en el festejo de los 30 años, También en los aportes de Moraes (2016) y Valenzuela (2016), que fueron elaborados para el II Congreso de la FCPN y finalmente dos documentos del Instituto de Ecología (2020, 2021). Se completaron detalles e información complementaria para editar la versión final, como un homenaje para esta carrera universitaria. Si bien se trató de resumir y considerar información relevante para este importante aniversario, seguramente se obviaron otros momentos y situaciones que sucedieron en estos años. Agradecemos a quienes compartieron fotos para ilustrar esta memoria.
A continuación, se incluye la presentación histórica de la Carrera de Biología de la UMSA - considerando elementos relacionados con su creación, estructura, funcionamiento y dinámicas importantes con el componente académico. También se incluye la información del Instituto de Ecología y el Instituto de Biología Molecular y Biotecnología respecto a sus unidades de investigación, realzando sus avances, desarrollo y logros. Finalmente, se incluye un acápite sobre la producción científica de la Carrera de Biología en su conjunto.
La Carrera de Biología (Esther Valenzuela C., Mónica Moraes R., Emilia García & Carlos Molina)
Antecedentes y creación
En Bolivia, existen cinco universidades, todas del Sistema de la Universidad Boliviana (SUB), que tienen Carreras de Biología: la Universidad Mayor de San Andrés (UMSA), la Universidad Mayor de San Simón (UMSS), la Universidad Autónoma Gabriel René Moreno (UAGRM), la Universidad Amazónica de Pando (UAP) y la Universidad Autónoma San Francisco Xavier de Chuquisaca. Al conformar el SUB en la formación universitaria, la Carrera de Biología de la UMSA tiene la función de formar profesionales con conocimientos científicos sobre la vida en todas sus manifestaciones para investigar, aplicar conocimientos, desarrollar tecnologías y/o educar en torno a los seres vivos. Pertenece a la Facultad de Ciencias Puras y Naturales (FCPN), junto con las carreras de Física, Química, Matemáticas, Estadística e Informática.
En la gestión de 1972 y gracias a la motivación de Rectorado de la UMSA, fueron convocados Juan Arellano (dentista), médicos y bioquímicos Juan San Martín, Edgar Romero, Jaime Flores y José Lorini (agrónomo) con el encargo de crear el departamento de Biología. En 1974 fue organizado el I Congreso - El Hombre y la Biosfera (MAB de la UNESCO); esta iniciativa estuvo a cargo de Gastón Mejía del Centro de Promoción de la Investigación Científica (CEPIC). Luis F. Hartmann del Instituto de Genética y Carlos Aguirre del Instituto de Física Cósmica de la UMSA. En reuniones junto a expertos extranjeros, surgió la posibilidad de consolidar la creación de centros de investigación y la formación de profesionales altamente capacitados en temas discutidos en ese Congreso, que fueron la base para crear al Instituto de Ecología. Finalmente, las intervenciones militares que se dieron en las universidades bolivianas (1976 y 1980) también significaron un periodo de estancamiento porque se reemplazó a parte del personal docente por otro improvisado. Predominaron condiciones de inestabilidad y discontinuidad en las actividades académicas por la vigilancia y persecución de docentes y estudiantes de otras carreras.
La organización y funcionamiento de la Carrera de Biología se basa en los principios, fines y objetivos de la Universidad Boliviana, especialmente en la autonomía universitaria y el cogobierno paritario docente-estudiantil, así como en la organización de la FCPN, de manera que en orden de jerarquía la Carrera tiene la siguiente estructura:
a) Congreso de Carrera y Asamblea General Docente Estudiantil.
b) Consejo de Carrera.
c) Dirección de Carrera.
d) Direcciones de Carrera: Académica, Investigación e Interacción Social.
Además, existen instancias paritarias de lineamiento, coordinación y planificación de investigación los consejos técnicos del Instituto de Ecología (IE) y del Instituto de Biología Molecular y Biotecnología (IBMB) (ver más adelante la memoria de creación de ambos). Posteriormente, durante el primer Congreso Interno de la Carrera de Biología en 2000, se motivó la conformación de varias comisiones y grupos de trabajo entre docentes y estudiantes para la discusión y recomendaciones en jornadas de sesión permanente, que estuvieron nutridas de documentos, como resoluciones y reglamentos internos, tanto a nivel académico como administrativo que todavía están vigentes. Uno de estos documentos impulsó la creación del IBMB, bajo gestiones de Gloria Rodrigo y el equipo que la acompañó.
Creación
La Carrera de Biología de la UMSA fue creada el 21 de septiembre de 1972 con el fin de contar con profesionales en ciencias biológicas dentro de la FCPN la cual ya tenía varios años formando profesionales en ciencias físicas, químicas y matemáticas. En un principio el plantel docente era limitado y conformado por profesionales en salud y agronomía. Posteriormente se incorporaron algunos profesionales biólogos, mayormente extranjeros residentes en el país (alemanes y franceses, ver más detalles en Instituto de Ecología) y otros profesionales en disciplinas biomédicas. Entre los nombres que quedan en la memoria institucional se tiene a Juan Arellano, José Lorini, Carlos Rocha, Rubén Rocha, Juan San Martín, Fernando Zuna, Ciro Simoni, entre otros. Desde los 80s se sumaron a este plantel profesionales con formación en ciencias biológicas, como Cécile B. de Morales, María Marconi, Patricia Cubillo, Javier Cerdá SJ y Mario Baudoin. Los primeros biólogos de la UMSA fueron Cristina Ruíz, Juan Pablo Arce, Franklin Koya, Esther Valenzuela, Emilia García, Lilian Villalba y Patricia Ergueta, entre otros; desde los 90’s, la mayor parte de ellos ha conformado el plantel docente de la Carrera de Biología y fueron investigadores del IE.

Izq.: Carlos N, Marco O. Ribera, Juan Pablo Arce, Fernando Zuna, Esther Valenzuela y Ciro Simoni. Der.: Rossy de Michel, Esther Valenzuela, Emilia García, Patricia Amurrio, Cristina Ruíz y Gonzalo Reyes.
En 1978, la Carrera de Biología bajo convenios suscritos por la UMSA, se potenció en el campo de la investigación. Por ejemplo, gracias al convenio establecido con la ORSTOM (que es la cooperación científica del Gobierno Francés, actualmente denominada IRD) se creó la División de Hidrobiología (hasta 1980), que generó varias actividades y proyectos mayormente concentrados en el Lago Titicaca, con el aporte de Gérard Loubens y Laurent Lauzanne, además de dos pescadores: Ramón Katari y Julio Huañapaco. También mediante el convenio con la Universidad de Gottingen de Alemania Federal con el financiamiento de la Cooperación Alemana (GTZ, ahora GIZ) se consolidó el funcionamiento del Instituto de Ecología (ver más adelante). Posteriormente fue el turno del Instituto de Biología Molecular y Biotecnología (ver más adelante).
Despliegue y desempeño
En 1991, la Carrera de Biología tuvo el encargo de coordinar la organización del I Congreso Nacional de Carreras de Biología en La Paz. La convocatoria fue lanzada a los proyectos e investigadores a nivel nacional y se presentaron trabajos en que se actualizaron los avances logrados en universidades bolivianas, así como por invitados internacionales. En los últimos 20 años, la carrera ha participado como coauspiciadora de varios eventos científicos como los congresos bolivianos de Ecología, Botánica, Mastozoología, Ornitología y Herpetología, con una amplia participación de docente-investigadores, tesistas y estudiantes en general.
Una gran parte de los profesionales biólogos conforma el Colegio de Biólogos de La Paz, que fue creado a fines de los 90s. En la década de los 2000 conformó la Red de Educadores y Profesionales de la Conservación del Museo Americano de Historia Natural en Nueva York para generar materiales educativos sobre diversos temas relacionados con la biología de la conservación y en que algunos docentes investigadores fueron coautores. Finalmente, como respuesta a convocatorias internacionales, en 2019 se participó en el Reto Ciudad Naturaleza mediante despliegue de registro de plantas y animales en el radio urbano de la ciudad de La Paz, compitiendo entre 160 países del mundo; fue la segunda ciudad con mayor número de observaciones y quedó en tercer lugar por su alto número de participantes. En la participación de 2022, alcanzó el primer lugar en tres categorías del Reto.
Componente académico
La Carrera de Biología ha planteado la oferta de programas curriculares que han sido adaptados en planes de estudio, según criterios relacionados a la diversificación de áreas del conocimiento y especialidades, al mercado laboral, a oportunidades de colaboración, entre otros. Al inicio de la carrera, como Departamento de Biología, se implementó el plan de estudios 1972, que tuvo modificaciones en el año 1974 y se concretó en el plan 1979, estructurado en tres ciclos, que ofrecía un título intermedio de Técnico Superior, completando ocho semestres de estudio y la preparación de una monografía y el título de Licenciado en Biología, con diez semestres de estudio y el desarrollo y defensa de una tesis científica. Este plan tuvo algunas modificaciones de forma entre 1982 y 1983 y después de jornadas académicas que generaron análisis con los docentes y autoridades de la Carrera. Por lo que se concretó el Plan de Estudios 1997 con 10 semestres de duración y ordenado en tres niveles: básico, medio y especialización. Además, se mantuvo el titulo intermedio de Técnico Superior, que posteriormente fue modificado a nivel de la Facultad por el de Bachiller en Ciencias y culminaba con la presentación de la tesis para optar al título de Licenciado en Biología.
Entre 2003-2004, se instauró un proceso permanente de análisis y renovación del plan de estudios de Biología, que fue financiado por el Fondo de Mejoramiento de la Calidad de la Enseñanza (FOMCALIDAD) del Viceministerio de Educación Superior. Esta experiencia favoreció la revisión de la estructura de toda la Carrera de Biología, así como la relación de la investigación y la docencia en base a un currículo por competencias. En este proceso se consideró las características de la Carrera de Biología y las modificaciones y adecuaciones de las corrientes mundiales sobre diseños curriculares en ciencias. En los talleres se llegó por consenso a adoptar un modelo de currículo que pueda relacionar estos procesos y ampliar las posibilidades de formación de los estudiantes, permitiendo una inserción de calidad en la práctica profesional, a través de la demanda del mercado y las necesidades del entorno socio-cultural. Se concretó este trabajo en un documento, “Currículo 2005”, acreditado por la UDUAL (Unión de Universidades de América Latina y el Caribe), que estuvo vigente hasta el 2016.
Bajo el pensum 2017, la actual formación académica en pregrado otorga el título de Licenciatura en Biología, al finalizar el octavo semestre y habiendo realizado la tesis de grado, otras modalidades son por excelencia y trabajo dirigido. Está conformada por 65 materias troncales y electivas; el último semestre es dedicado a la realización de la tesis de Licenciatura. En concordancia con visiones actuales de formación continua, incluye la formación en posgrado, que culmina con el título de Maestría en Biología y que a la fecha ya cuenta con tres versiones.
Acompañando la formación de nuevos profesionales, la Carrera de Biología instauró a lo largo de su historia varias generaciones de tutores, asesores y tribunales que consolidaron el respaldo para que jóvenes investigadores obtengan su grado académico en diversas especialidades y disciplinas de la biología. Al presente se han difundido dos ediciones sobre el resumen de las tesis de licenciatura en biología y de maestría en ecología y conservación, la última edición de 2010 cuenta con 289 registros de las tesis de pregrado y 51 registros correspondientes a las tesis de postgrado. En el período del 2010 a 2022, se incrementaron 196 tesis de pregrado, haciendo un total de 485 tesis en pregrado. En este mismo periodo se presentaron 51 tesis de postgrado, haciendo un total de 102 tesis. Entre el número de las tesis de maestría, 12 corresponden a la Maestría de Biología, defendidas entre noviembre del 2020 a diciembre del 2022.
A lo largo de los 50 años de vigencia de esta importante Carrera, los grupos de estudiantes han fluctuado ampliamente. desde cinco estudiantes en el primer año de su creación hasta 300-400 en los últimos años (Fuente: Dirección del Sistema de Información y Estadística de la UMSA, DSiE 2022, https://dsie.umsa.bo/). Este número que permite establecer procesos de enseñanza - aprendizaje de mayor calidad, gracias a la relación del número de estudiantes por asignatura, especialmente en los ciclos medio y superior.
En cuanto al número de ingreso de estudiantes nuevos, se registra que en los años 2012-2019 el número alcanzaba a un promedio de 50 nuevos y a partir del año 2020 llega a más de 80 estudiantes. Un dato interesante es el incremento de estudiantes mujeres, que en los años 90’s llegaba al 50%, a partir del año 2002 hasta el presente, alcanza el 65% (DSiE 2022). Considerando los años de permanencia en la carrera, solo el 5% está por encima de 10 años, la mayoría permanece entre 5 y 9 años (DSiE) y el promedio de titulados llega alrededor del 9% por gestión.
Actualmente, la Carrera de Biología cuenta con 33 docentes, de éstos 29 son docentes titulares, contratados bajo normas universitarias y con diferente asignación de carga horaria, siendo la mayoría a tiempo completo. En este grupo de docentes, se tienen profesionales con el grado de doctor en ciencias, maestría, especialidad y licenciatura. Son especialistas en diversas áreas de la biología y ecología, lo que permite organizar un conjunto de conocimientos relacionados con el avance científico y enfocado en el contexto local.
Un espacio para la búsqueda de información de estudiantes, egresados y docentes es la biblioteca “Erika Geyger” que inició sus actividades alrededor del año 1984, con base a adquisiciones realizadas por proyectos, investigadores y también por donaciones e intercambio. Consta de libros de texto sobre diferentes temas, revistas científicas y tesis de pregrado y postgrado. Gradualmente fue incrementando y actualizando sus servicios para la comunidad universitaria y público en general a lo largo del desarrollo de la carrera. Según directrices universitarias, utiliza el sistema de Bibliotecas KOHA, para el almacenamiento de datos y la plataforma de búsqueda OPAC. Con estas herramientas se ha actualizado la base de datos que a la fecha cuenta con 5279 registros, entre libros, artículos científicos y otros. Es importante mencionar que la biblioteca de Biología es parte del SUI-UMSA, que otorga facilidades para los usuarios como la búsqueda rápida y el acceso a recursos electrónicos de información.
Infraestructura
En la primera etapa de funcionamiento para la implementación de clases, laboratorios e investigación de la Carrera de Biología en sus inicios, los ambientes asignados para su funcionamiento fueron un aula y dos laboratorios en el edificio de la FCPN de la Av. Villazón. En 1984, se trasladó a ambientes del campus universitario en Cota Cota compartiendo espacios en el tinglado con Química. Entre 1996-1998 se construyó el primer edificio de la carrera, financiado en paite para la obra gruesa por la GiZ y fondos de la Corporación de Desarrollo de La Paz (CORDEPAZ), posteriormente y para la obra fina con fondos logrados de la cooperación inglesa obtenidos por Biología. En 2014 y gracias a financiamiento IDH - destinado a infraestructura universitaria - fue entregado un nuevo edificio para la Carrera de Biología que incluye instalaciones acondicionadas para clases y distribución de espacios acorde al desarrollo de nuestra comunidad y al plan de estudios vigente en esa época.
Investigación
En investigación, la Carrera de Biología tiene los objetivos generales de incrementar el conocimiento de las ciencias biológicas y aplicadas a través de la implementación de proyectos de investigación y la capacitación de recursos humanos altamente competentes, de implementar proyectos de investigación en biología, ecología y medio ambiente, así como en biología molecular y biotecnología, desarrollar las unidades de investigación con la búsqueda de financiamiento externo y proponer respuestas a las condiciones socioeconómicas de las diferentes regiones del país, impulsando el desarrollo armónico y planificado. Gracias a la repartición de los fondos del Impuesto Directo a los Hidrocarburos (IDH) al sistema universitario de Bolivia, los proyectos de investigadores de la Carrera fueron beneficiados entre los años 2009 y 2019. Sin embargo, esa búsqueda financiera por ambos institutos de investigación es permanente y constante para asegurar la implementación de proyectos y programas.
La Carrera de Biología busca trabajar en grupos inter y transdisciplinarios mediante el desarrollo de sus institutos de investigación, tanto a nivel de la UMSA como con otras universidades del país y del exterior, así como con sectores gubernamentales y con organizaciones no gubernamentales. Por ejemplo, ha desarrollado proyectos conjuntos con la Carrera de Química relacionado con el estudio de metabolitos secundarios y otras moléculas en plantas de interés medicinal, alimenticio u otros (por ej. el Proyecto Baccharis), con la Carrera de Física (efectos de la radiación UV-B en plantas, la Carrera de Bioquímica y Farmacia (plantas de uso medicinal tradicional), con Arquitectura (Ecología urbana y paisajismo), además de proyectos de instituciones gubernamentales (Ministerio de Salud y Deportes, - proyecto Enfermedades emergentes) (Ministerio de Medicina Tradicional - Vademécum de plantas medicinales) y no gubernamentales (WCS, ACCEA). Estas experiencias y sinergias fortalecen la construcción de conocimientos y el logro de los objetivos de las instituciones participantes.
Entre otras actividades de la vida universitaria, la Carrera fue parte de la implementación y desarrollo del Programa Integral Biológico Turístico - Jardín Botánico Tumupasa (PIBT-JB), en Tumupasa (Prov. Iturralde) entre 2010 y 2018. Este programa interdisciplinario, tenía como propósito reunir la experiencia de varios estudios e investigaciones realizadas en la Amazonia y promover proyectos para el desarrollo integral, conservación y rescate de la biodiversidad, los conocimientos y la cultura tradicional del pueblo Tacana. En 2010, respondiendo a una invitación del Rectorado de la UMSA, la Dirección de Carrera fue parte de este Programa hasta 2018, conformando el comité de apoyo técnico-administrativo y como responsable del pilar de conservación, biodiversidad y medio ambiente. Se participó en la generación e implementación de las políticas de desarrollo del programa, tanto académicas como administrativas. También fueron invitados otros profesionales de la Carrera en el comité de asesores para la supervisión de trabajos de investigación en cada pilar.
Por ello, la Carrera de Biología ha acumulado a lo largo de estos 50 años, conocimientos y experiencia suficientes para comprender y resolver varios de los problemas ambientales y biológicos con un enfoque integral y sistémico, con capacidad para proponer acciones de prevención y soluciones a mediano y largo plazo. Sin embargo, todavía no ha sido completamente incorporada en grupos de análisis y niveles de decisión, tanto como sería deseable. Está previsto, a través del trabajo de sus unidades de investigación, desarrollar trabajos importantes como la Flora de Bolivia, acciones de monitoreo de ecosistemas, flora y fauna, biorremediación y restauración de cuerpos de agua (p.e. Lago Titicaca) y suelos, protección de fauna urbana y rural, prevención de enfermedades causantes de mortalidad infantil, detección de factores genotóxicos en plantas alimenticias y medicinales, entre muchos otros.
La Carrera ha incrementado su equipamiento para investigación más o menos desde los años 90s que fue un periodo de mayores oportunidades de financiamiento para proyectos biológicos, especialmente dirigidos a colecciones científicas y su conservación. Gracias a las gestiones de los directores de Carrera e Institutos, así como al esfuerzo de los investigadores de las diferentes unidades de investigación fue posible acceder a diferentes financiadores y lograr la compra de equipos destinados al acondicionamiento de aulas y laboratorios.
Interacción social
Las actividades de interacción social y extensión de la Carrera de Biología están orientadas a difundir los resultados obtenidos a través de la investigación científica y a concientizar a la población en general sobre los problemas relacionados al medio ambiente. Como parte de estas actividades, se desarrollan conferencias, cursos, publicaciones ocasionales en la prensa y otros medios de comunicación, exposiciones públicas, pronunciamientos, entre otros. También ha contribuido en eventos de difusión y extensión universitaria, convocados por la UMSA, la Dirección de Investigación, Postgrado e Interacción Social (DIPGIS), la FCPN, Física a Puertas Abiertas, entre otros.
En la gestión 2010, la Carrera de Biología tuvo por primera vez el logo distintivo institucional - mediante el lanzamiento de un concurso para los estudiantes de nuestra comunidad - que basaba la referencia a las cuatro mayores áreas de trabajo: botánica, zoología, ecología y genética. Para representar al 50vo. Aniversario de la Carrera, también se organizó otro concurso entre los estudiantes y es el símbolo de este hito histórico en la trayectoria y desarrollo de la primera Carrera de Biología en el sistema universitario del país.
La Asociación de Docentes de Biología
La Asociación de Docentes de la Carrera de Biología, se fue desarrollando de acuerdo a la coyuntura organizacional de la universidad y por el crecimiento paulatino de nuestra Carrera. Durante la década de los 80’s y 90’s, está representación recayó en la nominación de un representante docente, el cual era designado en una reunión de profesores y este a su vez era el portavoz de los intereses gremiales, siendo parte de los Consejos de Carrera y Facultativo. A partir del Primer Congreso Interno de la Carrera de Biología del año 2000, se reconoce a la Asociación de Docentes, como una agrupación elegida de docentes y se constituye como la representación habilita en el asesoramiento de los Consejos de Carrera y Facultativo.
El reconocimiento de esta organización al nivel de instancias superiores dentro y fuera UMSA, fue concebido en el XII Congreso Nacional de Universidades de 2014 y en nuestra Facultad de Ciencias Puras y Naturales a partir del II Congreso en 2016. Estas dos últimas reuniones universitarias, le dieron mayor legitimidad a esta agrupación de docentes, constituyéndose, junto con los centros de estudiantes, en entes de decisión en los consejos. Esta situación impulsó la conformación de diferentes fórmulas y carteras, que mediante propuestas de planes de trabajo sean elegidos democráticamente mediante la emisión y escrutinio de votos por parte de los docentes de base. En la actualidad, la Asociación de Docentes de la Carrera de Biología no sólo trabaja por los intereses académicos y gremiales, sino también se constituye en una de las instancias efectivas de seguimiento y control de las gestiones de las direcciones de institutos y de la Carrera de Biología.
El Centro de Estudiantes de Biología
Los estudiantes universitarios, como estamento y en concordancia con los estatutos de la UMSA, están agrupados y sus representantes son parte del cogobierno universitario. Esta representación es elegida cada dos años en procesos democráticos, organizados bajo normas del estamento estudiantil, que respaldan la conformación de Centros de Estudiantes. A lo largo del desarrollo de la carrera de Biología, han pasado numerosos centros estudiantes, iniciándose desde los años 1976-1978, que junto con la representación docente conforman el Consejo de Carrera y participan en Consejos Facultativos de la FCPN, donde se definen y analizan las políticas internas institucionales.
El Instituto de Ecología (Mónica Moraes R. & Esther Valenzuela)
Creación del IE
Mientras se organizó el primer congreso del MAB (Man and Biosphere de la UNESCO) en La Paz en 1974 y convocó a investigadores internacionales - como Erika Geyger y Barbara Ruthsatz por sus investigaciones en el norte de Argentina - se visualizaron opciones de colaboración entre la UMSA y la Universidad de Gottingen (Alemania). En 1976 se elaboró el documento del convenio a ser suscrito a cargo de José Lorini y Cecile de Morales, constituyéndose en el primer convenio para la creación del Instituto de Ecología, cuyo avance fue truncado debido al gobierno de facto en ese tiempo.
Desde el 11 de noviembre de 1978 fue registrada formalmente en la UMSA la creación del Instituto de Ecología en resolución universitaria y con ello, el inicio de su crecimiento y funcionamiento. Con el respaldo del convenio suscrito entre la UMSA y la Universidad de Gottingen (Alemania) el 4 de abril de 1978 - plantearon la organización institucional del IE. En su inicio se contó con financiamiento de la cooperación alemana (GIZ) que además abrió oportunidades financieras para completar tesis de pregrado en biología, junto al apoyo de los técnicos alemanes: Erika Geyger, Ekkehard Jordan, Michael Runge, Werner Hanagarth, Stephan Beck y Barbara Ruthsatz y docentes de la carrera de Biología, como José Lorini, Cécile de Morales - quien fue la primera directora del IE - , María Marconi, Máximo Liberman y otros. El Instituto de Ecología dependió en su inicio del CEPIC de la UMSA y luego pasó definitivamente a la Carrera de Biología. El arranque de esta institución fue el semillero para el desarrollo logrado a partir de un grupo de jóvenes investigadores de la Carrera de Biología que fueron parte de las primeras estructuras institucionales. El compromiso asumido por ese grupo inicial de investigadores fue determinante para lograr el crecimiento y diversificación otras áreas.
Como el Instituto de Ecología es parte de la Carrera de Biología, la estructura orgánica presenta instancias según normativa vigente en la UMSA, con participación docente y estudiantil. Su estructura organizativa es la siguiente (RI-IE 2019): a) Dirección, b) Consejo Técnico del IE, c) Comité Ejecutivo, d) Personal técnico, administrativo y de servicio (Apoyo) y e) Unidades de investigación. Así como se hace mención al trabajo de los docentes investigadores - de planta y asociados a las unidades y proyectos - también el personal administrativo y de apoyo ha sido parte de nuestra trayectoria. El trabajo desempeñado a nivel de investigación, interacción social y extensión universitaria en el IE muestra el compromiso de los funcionarios quienes conforman un equipo de trabajo valioso y de constantes dinámicas.
En cumplimiento con la definición instaurada por el SUB para organizar cursos de postgrado interdisciplinarios - en el año 1994 el Instituto de Ecología, implementó el primer curso de postgrado denominado Maestría en Ecología y Conservación, que tuvo la vigencia de 11 versiones con grupos de profesionales en varias disciplinas. Las convocatorias de esta maestría también involucraron a personal profesional de la Carrera. A partir de la gestión 2019, este programa ha sido transferido bajo tuición directa de la Carrera de Biología, incluyendo la infraestructura instalada en el Centro de Postgrado en Ecología y Conservación (CEPEC), así como el equipamiento adquirido.
Unidades de investigación del IE
Gracias a la colaboración alemana y francesa se tradujeron en el tiempo en la creación de cinco unidades dentro del Instituto de Ecología: Limnología (la antigua División de Hidrobiología), Suelos, Fisiografía, Botánica y Zoología. Estas dos últimas unidades, en los años 1984 y 1989 - respectivamente - y mediante la suscripción de convenios de colaboración entre la UMSA y la Academia Nacional de Ciencias en Bolivia para ser ejecutados por el Instituto de Ecología y el Museo Nacional de Historia Natural avalaron la creación del Herbario Nacional de Bolivia y la Colección Boliviana de Fauna. Ambas colecciones plantearon la necesidad de aunar esfuerzos en el relevamiento y conocimiento de la biodiversidad boliviana, custodiando colecciones científicas de flora y fauna de referencia a nivel nacional. Posteriormente el Instituto de Ecología implementó otras unidades denominadas de servicio desde los 90s: la Editorial, el Laboratorio de Calidad Ambiental, el Centro de Análisis Espacial y el Jardín Botánico La Paz. Revisiones subsecuentes del funcionamiento del Instituto de Ecología llevó a cerrar la Unidad de Fisiografía y crear la Unidad de Calidad Ambiental para alojar adecuadamente al Laboratorio de Calidad Ambiental.
El conjunto de los esfuerzos también consolidó los requerimientos en infraestructura, equipamiento y capacitación técnico-científica, que son cada vez más exigentes por la diversificación en áreas de especialidad y las limitantes financieras. Sin embargo, persiste el norte para continuar con el desarrollo institucional - que ahora está estructurado en cuatro grandes unidades: 1 Ecología Acuática (incluyendo a limnología y a calidad ambiental), 2 Ecología Vegetal y Botánica (con el Jardín Botánico y el Herbario Nacional de Bolivia bajo convenio), 3 Ecología Terrestre (clima, suelos, y 4 Ecología Animal y Zoología (con la Colección Boliviana de Fauna bajo convenio) - fluctuando anualmente entre 25-35 proyectos de investigación (Instituto de Ecología 2021). Las unidades de investigación del Instituto de Ecología que incluyen a personal de planta e investigadores asociados son (PEI-IE 2020):
U. Ecología vegetal y botánica: biología de plantas y factores ambientales, distribución y abundancia de plantas, interacciones, etnobotánica, conservación, fitogeografía, ecología poblacional y ecosistémica con respaldo de colecciones
U. Ecología animal y zoología: biología de animales y factores ambientales, distribución y abundancia de animales, interacciones, etnozoología, conservación, zoogeografía, ecología poblacional y ecosistémica con respaldo de colecciones
U. Ecología acuática: sistemas acuáticos y limnología, biogeoquímica y biotecnología, relación entre compuestos geoquímicos y organismos vivos, atmósfera, biomasa, ciclos de tipo sedimentario y gaseoso
U. Ecología terrestre: diversidad ecosistémica, bioindicadores, ordenamiento territorial, clima, relaciones tróficas y espaciales, ecología urbana, agroecología, edafología
Los 20 investigadores del Instituto procuran generar constantemente los resultados obtenidos mediante sus trabajos de investigación, ya sea mediante el envío de artículos originales a revistas indexadas nacionales o internacionales, libros, reseñas y la presentación de resúmenes de ponencias en memorias de eventos científicos; también en colaboración con otros institutos y centros de investigación. La lista de esas contribuciones científicas es larga y frecuentemente es incrementada por cada científico en su especialidad. Sin embargo, hay varios ejemplos en los cuales grupos de investigadores contribuyeron en la divulgación de libros, que permite también la conformación de especialistas en colaboración científica para actualizar el conocimiento sobre varios temas de la biodiversidad, ecología, naturaleza, gente, recursos, entre otros. En el aniversario 43vo. se difundieron los avances y logros que revisten la investigación biológica y ecológica basada en proyectos, actividades y producción intelectual del grupo de investigadores del Instituto de Ecología (Instituto de Ecología 2021).
A nivel nacional, el Instituto de Ecología ha conformado la Red de Investigación en Biodiversidad (convocada por el Viceministerio de C y T) desde 2009, junto a otros centros de investigación del país. Se ha participado en las reuniones convocadas por esa Red con el fin de estrechar lazos de cooperación con representantes de instituciones de todos los departamentos y que están involucrados en la investigación, documentación, conservación, manejo y otros temas sobre la diversidad biológica de Bolivia. También se ha registrado los avances y características del Instituto de Ecología en el “Potencial científico y tecnológico boliviano”, publicado por el Viceministerio de Ciencia y Tecnología del Ministerio de Educación en 2009, por lo que a nivel nacional figura en estadísticas de las tendencias sobre la investigación científica de Bolivia.
Además de la investigación, se ilustran tres capacidades instaladas que han fortalecido la divulgación de la producción científica, programas de interacción social en educación ambiental y la prestación de servicios, como sigue:
1 La revista Ecología en Bolivia: A partir de 1982, el Instituto de Ecología organizó comités editoriales para respaldar el funcionamiento de la revista científica “Ecología en Bolivia” y así difundir la producción científica, a nivel institucional y de la región. En sus primeros años contó con el coauspicio del Centro Pedagógico y Cultural Portales. Hasta 1994 fue beneficiada con financiamiento de la GiZ al Instituto de Ecología; entre 1995 a comienzos de 1997 se obtuvo el apoyo financiero del Fondo Nacional de Medio Ambiente (FONAMA) y desde fines de 1997, el Instituto nuevamente asignó fondos para la diagramación, impresión y envío. No solo se incluyen los dos números por año, sino que la revista también ha publicado números especiales de determinados proyectos del instituto. El material impreso fue distribuido a nivel nacional e internacional, bajo un programa de intercambio con aproximadamente 250 instituciones, editoriales y centros de investigación afines.
A partir de 2019 la revista únicamente es difundida en formato digital mediante dos plataformas, de la revista y de SciELO Bolivia. Hasta el presente se ha publicado el volumen 56 con dos números y gracias al esfuerzo generado por su Comité Editorial y en cumplimiento con exigencias editoriales bajo estándares internacionales y de frecuencia constante, “Ecología en Bolivia” ha logrado desde 2001 la indexación en varias colecciones, como Latindex, Periódica, Dialnet y desde 2008, en SciELO Bolivia.
2 El Jardín Botánico La Paz: Con el objetivo principal de contribuir a la conservación de la biodiversidad, la investigación científica, la enseñanza y la demostración de nuestros recursos vegetales, mediante una Resolución Rectoral en el año 1988, fue creado el Jardín Botánico “La Paz” y en 1991 fue inaugurado en el Campus Universitario de Cota Cota. Es una unidad que estructuralmente está relacionada con la unidad de Botánica, pues se desarrolló para acompañar la formación académica y la investigación, además de la interacción social y extensión universitaria con la organización de talleres, cursos de capacitación y guía de grupos en educación ambiental.
Conforma la Asociación Latinoamericana y del Caribe de Jardines Botánicos (ALCJB) y la Red Sudamericana de Jardines Botánicos (RSJB) en su desempeño ha logrado financiamiento de Holanda, Suiza y de la Organización Internacional de Jardines Botánicos (BGCI). El Jardín Botánico “La Paz” cuenta con un área de 5 ha del campus, divididas en cinco sectores en que se realizan trabajos continuos en jardinería y se desarrollan estudios ecológicos, edafológicos y morfoanatómicos de grupos específicos, además de ensayos tales como como formas de reproducción por estacas y por semillas de varios grupos y adaptación al cultivo de especies vegetales de valles secos.
3 El Laboratorio de Calidad Ambiental: Gracias a esfuerzos realizados mediante investigadores del Instituto, se planificó desde 1992 el funcionamiento del Laboratorio de Calidad Ambiental (LCA) con el fin de generar servicios con análisis físico-químicos confiables. Gracias a un importante financiamiento del Banco Mundial (BM) en 1997 - bajo convenio entre la UMSA y el Ministerio de Desarrollo Sostenible - el Instituto de Ecología fue beneficiado con la construcción de este Laboratorio, que fue instalado desde 2007. En 2002 mediante la evaluación de Organismo Boliviano de Acreditación (OBA) del Viceministerio de Industria y Comercio Interno, el LCA logró ser reconocido como el primer laboratorio universitario acreditado, en cumplimiento a normas NB ISO/IEC.
Se ha especializado en la realización de análisis químicos relacionados con la calidad ambiental en nuestro país, generando servicios para el Gobierno Municipal de La Paz, EPSAS, empresas privadas y otras instituciones. Realiza servicios de análisis ambientales certificados a instituciones estatales y privadas, así como asistir, apoyar y complementar las tareas de investigación y enseñanza que realiza este instituto. También se considera parte de sus objetivos, aportar con su tecnología, procesos y productos, a cualquier proyecto de desarrollo que contribuya al bienestar general de la población boliviana. Actualmente el LCA conforma a una subunidad, Calidad Ambiental, que también realiza investigación y genera información científica.
Avances y producción del IE
Con la oportunidad de generar investigación y organizar proyectos o programas científicos de acuerdo al desempeño de los grupos de trabajo del Instituto de Ecología, también el plantel de docentes investigadores fue conformado por profesionales mayormente biólogos que obtuvieron la licenciatura en la UMSA. Posteriormente, estos investigadores también procuraron la obtención de doctorados en varios países del extranjero (Alemania, Brasil, Argentina, Dinamarca, España, entre otros). Entre los ejemplos más representativos, se tiene a los trabajos de investigación desarrollados en Huaraco (Altiplano paceño), Reserva de Fauna Silvestre Espíritu (sabanas inundables del Beni), La Paz (valle interandino), Reserva de la Biosfera Estación Biológica Beni (Beni), Parque Nacional Madidi, Sapecho y Lago Titicaca (La Paz), Tariquía y valle central (Tarija), Oruro, Potosí; relevamientos rápidos en Madidi y Pando, entre otros.
Posteriormente en los 90s, se sumó como área permanente a la Estación Biológica Tunquini como sitio de investigación y capacitación en los Yungas de La Paz. Prueba de esas investigaciones se generaron diversas publicaciones, se organizaron eventos de discusión científica y se formaron nuevos profesionales. Desde su creación el IE ha participado en planes, programas y proyectos a través de la investigación, capacitación y asesoría técnica, para enfrentar y dar solución a los problemas del manejo y conservación de la biodiversidad y la gestión ambiental en Bolivia y en la región. Fue pionero en los acontecimientos y en la formulación de políticas y estrategias de conservación y manejo de recursos naturales renovables en Bolivia, pues sus grupos de expertos participaron en la discusión de varias leyes y normativas nacionales: Ley General de Medio Ambiente (1992), Ley General Forestal (1995), reglamentos, entre otras; también sus investigadores participaron en la definición de nuevas áreas protegidas, así como en los grupos interdisciplinarios para la elaboración de planes de manejo de áreas protegidas y la preparación del Plan de Acción Ambiental (1995), Informe Nacional sobre Recursos Fitogenéticos de Bolivia (1996), “Comunidades, Territorios Indígenas y Biodiversidad en Bolivia” (1996), la Estrategia Nacional de Conservación y Uso de la Biodiversidad y Plan de Acción de Bolivia (2002), así como en la publicación “Biodiversidad: La riqueza de Bolivia” (2004). A convocatoria de la Comunidad Andina de Naciones y mediante un consorcio interinstitucional, se produjo la Estrategia Regional de Biodiversidad para los Países del Trópico Andino (2002).
En su trigésimo aniversario (marzo de 2009), el IE organizó un simposio científico y convocó a investigadores cooperantes, así como profesionales del país, con el fin de aglutinar los resultados de investigaciones, aportes en discusiones sobre temáticas relacionadas con el quehacer institucional y la reunión de colegas, bolivianos y extranjeros.
Fue la oportunidad para realzar el avance logrado gracias al desempeño de varios proyectos de investigación, en su mayor parte junto a la cooperación científica con pares e instituciones afines, además de la capacitación y promoción de nuevos profesionales de pregrado y postgrado en las ciencias biológicas y ecológicas de nuestro país.
A nivel nacional, investigadores y expertos participaron en la evaluación del estado de conservación de varios grupos de la biodiversidad en Bolivia. Con el respaldo del Ministerio de Medio Ambiente y Aguas, en (2009) como parte de un proyecto internacional, se participó en la publicación del “Libro Rojo de parientes silvestres de cultivos de Bolivia”. En ese año también se publicó el “Libro rojo de vertebrados amenazados de Bolivia” con más de 135 especialistas. En 2012 salió “Libro rojo de plantas amenazadas de la zona andina” y en 2020 en el “Libro rojo de plantas amenazadas de tierras bajas”.
Además de numerosas publicaciones de artículos científicos en “Ecología en Bolivia” y otras revistas indexadas con impacto (a ser presentados más adelante), los investigadores del IE han producido varios libros, manuales, guías, informes técnicos y referencias basadas en las investigaciones de diversos proyectos y programas. Estas publicaciones derivan del trabajo de campo y laboratorio que fueron parte de la colaboración científica con otros pares académicos, otras instituciones y centros de investigación y con el auspicio de varias fuentes de financiamiento. Varias de ellas son ediciones internacionales con capítulos que incluyen a Bolivia o a evaluaciones regionales donde participaron autores bolivianos.
La colaboración científica se ha consolidado con varias instituciones similares en otras universidades de Bolivia, así como de otros países. No solo se incluyeron publicaciones, sino la formación en pre y postgrado de los estudiantes que fueron incluidos con el fin de obtener grados académicos en varias disciplinas.
Infraestructura
Como sucede con los institutos de investigación del sistema universitario, uno de los desafíos más apremiantes es la infraestructura y habilitación de espacios que acompañen el desarrollo científico, la formación de nuevos profesionales y el desempeño profesional de sus investigadores. Al comienzo de su funcionamiento, fue instalado el IE en un departamento alquilado por la UMSA y diferentes unidades fueron concentradas en oficinas y cuartos de la calle Juan José Pérez: botánica, geografía (luego zoología), climatología, además de una biblioteca, salón de clases y reuniones, así como dos laboratorios.
Desde el primer ambiente que dispuso el IE, los esfuerzos se incrementaron en proporción a las unidades, al grupo de investigadores y a la generación de proyectos en forma permanente. En varios espacios se invirtió en la construcción de las oficinas de la dirección del IE, el garaje el auditorio con varios depósitos y que hoy también alojan a espacios para investigación, el edificio de limnología, el CAE, el edificio del Laboratorio de Calidad Ambiental y la disponibilidad de los
predios en el campus universitario para alojar al Jardín Botánico. Gracias a la Carrera de Biología y correspondiente apoyo de la FCPN, el IE ocupó una mitad de uno de los tinglados en el campus universitario de Cota Cota para alojar a varias unidades: botánica, fisiología, editorial, suelos y ambientes para oficinas y depósitos. Con el apoyo de la UMSA y la cooperación de otras instituciones, se construyó el edificio para la unidad de zoología - en que funcionó la Colección Boliviana de Fauna - pero en poco tiempo sufrió las consecuencias del asentamiento en Cota Cota y colapsó. Por ello fue necesario organizar un proyecto de mayor dimensión y con futuro: Parque Científico; sin embargo, la FCPN respaldó que las oficinas y espacios de la colección zoológica ocupara algunos ambientes en el edificio facultativo del predio de Cota Cota.
Entre 2011 y 2012 - gracias a financiamiento con fondos IDH asignados por la UMSA al IE, a través de la carrera de Biología - se construyó el primer bloque de un complejo de infraestructura denominado “Parque científico” con respaldo de un proyecto y diseño arquitectónico para alojar a las colecciones de flora y fauna, así como oficinas y áreas de difusión. Con esta primera fase y con financiamiento adicional logrado por la unidad de Ecología Vegetal y Botánica entre 2019-2021, se ha completado la segunda planta en que fue trasladado una parte del Herbario Nacional de Bolivia. También se iniciaron inversiones para acondicionar la primera planta en que podrá funcionar laboratorios y ambientes destinados a las colecciones zoológicas de la Colección Boliviana de Fauna, obtenidas en varias regiones de Bolivia.
Reconocimientos
El Instituto de Ecología posee un lugar trascendente y reconocido a nivel de los institutos universitarios de Bolivia y en el contexto internacional está conceptuado como uno de los centros de investigación y formación más importantes del área andina y en la amazónica. Es así que actualmente el Instituto de Ecología es un centro líder en Bolivia de investigación científica y formación universitaria, que depende de la Carrera de Biología en La Paz. Ha recibido varios reconocimientos en su trayectoria que motivan el desempeño de los grupos de sus investigadores y el planteamiento de innovar y actualizar sus lineamientos científicos. Entre esas distinciones se tiene a las emitidas por el Gobierno Municipal de La Paz, CEUB, FUNDESNAP y otros.
Instituto de Ecología. 2020. Plan estratégico institucional 2020-2024. Universidad Mayor de San Andrés, La Paz. 28 p.
Instituto de Ecología. 2021. Mis experiencias como investigador/a en el Instituto de Ecología. Instituto de Ecología, Universidad Mayor de San Andrés, La Paz. 165 p.
Morales, C.B. 2008. Memorias de 30 años (1978-2008) del Instituto de Ecología - UMSA. Instituto de Ecología, Universidad Mayor de San Andrés, La Paz. 80 p.
Moraes R., M. 2016. Instituto de Ecología. Insumo elaborado para la Memoria Institucional 1966-2016, Facultad de Ciencias Puras y Naturales, Universidad Mayor de San Andrés, La Paz. 35 p.
Valenzuela C., E. 2016. Carrera de Biología. Insumo elaborado para la Memoria Institucional 1966-2016, Facultad de Ciencias Puras y Naturales, Universidad Mayor de San Andrés, La Paz.
El Instituto de Biología Molecular y Biotecnología (Isabel Morales & Sergio Gutiérrez-Cortez)
En 1990 la Unidad de Biología Molecular del Instituto de Genética de la Carrera de Medicina de la UMSA se fusionó a la Carrera de Biología, con esta fusión, se estableció el área de Biología Molecular y disciplinas relacionadas que complementan el perfil de docencia e investigación con tres metas generales 1) Contribuir a la formación de una visión integradora de las ciencias biológicas, acorde a su desarrollo en el mundo, a través de la actualización de conceptos e introducción de nuevas tecnologías 2) Crear mecanismos para aplicar el conocimiento básico y generar y potenciar biotecnologías en áreas de prioridad nacional 3) Participar en la formación de recursos humanos especializados en el área de genética, biología molecular y ramas relacionadas.
En esta unidad el programa se enfocó en la investigación en Biología Molecular de Bacterias y Virus, y se desarrollaron las bases metodológicas para el desarrollo de la Biología Molecular, se realizaron los primeros trabajos en este campo en Bolivia y se introdujeron nuevos conceptos y metodologías a varias ramas de las Ciencias Biológicas. Posteriormente, se crearon las líneas de investigación en Genética de Poblaciones y Vigilancia Ambiental y la Unidad de Biotecnología Vegetal, originalmente independiente, pasó a formar parte del grupo de investigación desde el año 2000.
En diciembre/2000, finalizaron las obras para acondicionar diferentes laboratorios y oficinas en sus instalaciones localizadas en el campus universitario de Cota Cota. Esta obra fue posteriormente remozada con fondos IDH en 2014, junto a otra infraestructura en la Carrera.
Durante el desarrollo del I Congreso de la Carrera de Biología en 2000, se planteó la conformación del Instituto de Biología Molecular y Biotecnología, tomando como base las líneas de investigación creadas y en funcionamiento. En noviembre/2000, se emitió la resolución del Consejo de Carrera de Biología, aprobando la formación del IBMB, que fue refrendada por el Honorable Consejo Facultativo y luego por la Resolución del Honorable Consejo Universitario 010/2003. A partir de esta cronología documentada, obtuvo la categoría de instituto de investigación de la UMSA, formalizando los esfuerzos generados mediante los proyectos y publicaciones que fueron generados por sus investigadores.
Unidades de investigación
A partir de la consolidación del IBMB, las líneas de investigación existentes se van constituyendo en unidades: U. de Enteropatógenos, U. Biología Evolutiva, U. Vigilancia Ambiental y Genotoxicología y U. de Biotecnología Vegetal. En 2004 se adiciona la unidad de Microbiología Ambiental y en 2008 la unidad de Biotecnología Ambiental. Desde 2008, el IBMB se organizó en seis unidades a través de las cuales se desarrollan sus líneas de investigación. Estas son:
Biología molecular de virus y bacterias: realiza investigación sobre virus y bacterias causantes de enfermedades gastrointestinales y respiratorias. Entre los principales logros de la unidad podemos nombrar : el desarrollo e implementación de sistemas de diagnóstico molecular para diferentes enteropatógenos causantes de Enfermedades Diarreicas Agudas (EDA) en niños menores a 5 años, el relevamiento continuo de datos de Epidemiología molecular del Rotavirus y EDA a nivel nacional, la implementación, junto al Ministerio de Salud y OPS, de la Vigilancia de rotavirus en niños menores a 5 años hospitalizados por EDA, el diagnostico sistemático de rotavirus, norovirus como servicio de apoyo a hospitales pediátricos, el desarrollo de un kit ELISA casero para rotavirus. Se ha aportado asimismo con datos clínico- epidemiológicos y moleculares para fundamentar la introducción de la vacuna RV1 en nuestro país, se ha estudiado la carga económica de la EDA por rotavirus a las familias en Bolivia y se realiza la evaluación de impacto de la vacuna RV1 en la mortalidad y morbilidad por EDAs así como la evaluación de marcadores nutricionales y de inflamación y enteropatógenos en niños menores a un año de la ciudad de El Alto. Por otro lado, se ha analizado el impacto de la contaminación por coliformes termotolerantes, enteropatógenos y resistencia a antibióticos en la cuenca del Rio La Paz y enteropatógenos en camélidos sudamericanos (CSA) de importancia para la inocuidad alimentaria. A partir del año 2021, la unidad realiza la detección e identificación de variantes de SARSCOV2 por secuenciación Sanger.
La Unidad participa en programas de postgrado como la Maestría en Ciencias Biológicas y Biomédicas, Master in Global Health University of Emory USA, programas de doctorado sandwich en los que intervienen la UMSA y las universidades suecas de Goteborg, Lund y el Karolinska Institute. Gracias a esta participación se han graduado cinco personas del doctorado y se han formado varias generaciones de estudiantes que han obtenido maestría. Los financiamientos obtenidos para los diferentes proyectos de investigación realizados han permitido la adquisición de equipos que permiten realizar trabajos en biología molecular como ser termocicladores, termocicladores de tiempo real, microscopio de epifluorescencia, secuenciador ABI, ultra freezers.
Vigilancia ambiental y genotoxicología se enfoca en dos áreas. La primera en temas relacionados al efecto que tienen los contaminantes ambientales sobre el material genético de organismos vivos; estos análisis se realizan usando bioindicadores, como células vegetales, células de peces, Drosophilas o células de cultivo. Se analizan aguas, suelos, alimentos contaminados con diferentes compuestos, como plaguicidas, metales pesados u otros contaminantes sintéticos o naturales, como aflatoxinas y otros productos que pueden causar mutaciones en el ADN de nuestras células.
La segunda área se enfoca en estudios del potencial que tienen plantas, frutas y moléculas aisladas de estos en atacar a las células tumorales y provocar su muerte, tratando de entender el mecanismo de muerte (en cultivos in vitro de células tumorales), además se evalúa el potencial genotóxico y/o antigenotoxico de estas muestras, considerando las recomendaciones de la OMS de consumo seguro de plantas medicinales. Para esto el análisis se realiza con una batería de ensayos que emplean bacterias (Test de Ames), insectos como Drosophila melanogaster (Test de mutación y recombinación somática en alas de Drosophila), células de plantas (test de micronúcleos y anomalías nucleares) y cultivos de células animales (test de micronúcleos y electroforesis de una sola célula). Las investigaciones en esta unidad son auspiciadas por la cooperación sueca ASDI, OEA, Cosude (Suiza), Universidad de Gante (Bélgica) y fondos IDH.
La Unidad participa en la Maestría en Biología mediante el dictado de la materia de Genotoxicología y como parte del curso de genotoxicología de la Maestría en Ciencias Biológicas y Biomédicas. Gracias a los proyectos con financiamiento ASDI, se han formado dos doctores y un doctorado está en curso. Se cuenta con dos graduados de la Maestría en Biología y tres maestrantes en curso. Se ha realizado un gran número de tesis de licenciatura. El financiamiento de los proyectos de investigación ha permitido la compra de microscopio invertido, destilador de agua miliQ, estufa de cultivo de CO2, campana de flujo laminar, microscopio de fluorescencia entre otros.
Dentro de los proyectos se han realizado actividades de interacción social, como ser talleres con las comunidades sobre la contaminación de la cuenca Katari, trabajo con los estudiantes de último año de los colegios de la Bahía Cohana, Viacha y lugares aledaños y cursos de capacitación a técnicos de las alcaldías. Algunas de las fotografías muestran estas actividades de socialización y capacitación. En el proyecto Evaluación transdiciplinaria del efecto de los metales pesados en humedales de la cuenca Katari y sus consecuencias en organismos vivos, talleres en Cohana con las comunidades y cartilla explicativa del hongo del sol de alta calidad en la comunidad Nogalani Azucarani:
Biología evolutiva (UBE). Estudia la diversidad genética y los procesos evolutivos de la diversificación en poblaciones de diferentes especies domésticas y silvestres con fines de conservación y manejo.
Inició sus actividades de investigación a partir del año 2000, en poblaciones de peces de la amazonia de Bolivia, a nivel genético poblacional, a través de tecnologías de punta en marcadores moleculares con financiamiento del IRD. Posteriormente, la Unidad (UBE) diversificó sus líneas de investigación al análisis genético poblacional de varias especies domésticas y especies silvestres. Se creó la línea de investigación sobre el estudio genético de camélidos sudamericanos en el año 2004, aplicando marcadores moleculares sobre algunas poblaciones naturales.
Luego, a través de la interacción de varias instituciones nacionales (UTO- Banco de Germoplasma de Camélidos de Bolivia, Ministerio de Desarrollo Rural y Tierras, Ministerio de Medio Ambiente y Aguas, Municipios departamentales, productores de camélidos) e internacionales (Universidad Agraria La Molina, Universidad de Boku, Universidad de León, entre otras), con financiamiento tanto interno como externo (IDH, FAO, ASDI-SAREC, AECI), esta línea de investigación se fortaleció para desarrollar trabajos de investigación sobre poblaciones de todas las especies de camélidos de Bolivia, abarcando el área total de su distribución, utilizando herramientas genéticas y análisis estadísticos poblacionales refrendados y evaluados por pares internacionales a través de varias publicaciones en revistas internacionales.
En los últimos años, producto de las colaboraciones y resultados obtenidos, se tiene en curso el proyecto de análisis genómico de los camélidos sudamericanos bolivianos, financiado por la cooperación sueca, para profundizar los análisis genético poblacionales de variabilidad y estructura genética y, a futuro, realizar estudios de asociación por selección genómica que sirvan de base a las instituciones nacionales implicadas en estos recursos genéticos para programas de conservación y manejo.
Por otro lado, en el caso de la línea de investigación de los estudios genéticos sobre poblaciones de especies silvestres, se iniciaron estos trabajos en el año 2005 en interacción y financiadas por la WCS, Fundación PUMA, Dirección General de la Biodiversidad, para el análisis de especies endémicas, especies en peligro de extinción o vulnerabilidad, a través de estudios genético poblacionales y aplicando diferentes tipos de marcadores moleculares.
Los programas de Maestría y Doctorado en los que participa la UBE son la Maestría de Ciencias Biológicas y Biomédicas, Maestría Terminal de Ciencias Biológicas de la Carrera de Biología, Maestría de Ciencia Animal de la Facultad de Agronomía, Maestría en Camélidos de la UTO y en el Programa de Doctorado de ASDI-SAREC. Asimismo, la UBE ha participado en la formación de 7 estudiantes de maestría y 2 doctorados, así como la formación de una decena de estudiantes a nivel de pregrado. Los cursos en los que participó la UBE como organizador en relación a las interacciones nacionales e internacionales se encuentran: Curso de Aplicación de Marcadores moleculares para estudios de manejo y Conservación realizado en Lima, Perú. El mismo fue replicado también en la Universidad Técnica de Oruro, Curso de Investigación Participativa desarrollado en la UMSA, Curso Internacional de introducción al Mejoramiento Genético desarrollado en la UMSA.
Las actividades de interacción social promovidas por la UBE, se enfocan al trabajo con las comunidades de productores de camélidos en el área rural, así como también con autoridades municipales en varias zonas del altiplano boliviano como Curahuara de Carangas, Turco, Totora, Catacora, Ulla Ulla, Santiago de Machaca, Jesús de Machaca, Cocapata, Sud Lípez, etc. Para la implementación de estas líneas de investigación en la UBE, han sido necesarios contar con equipos de envergadura como termocicladores, centrífugas, transiluminadores, fuentes de poder, etc., equipo y reactivos imprescindibles que, en el área de biología molecular, tienen costos elevados.
Microbiología ambiental. Ha desarrollado investigaciones relacionadas a la detección molecular y cultivo de bacterias sulfato-reductoras presentes en ecosistemas acuáticos de la amazonia y el Altiplano; esto, con el apoyo del IRD, OEA y financiamientos IDH. En el año 2014, a través de proyectos IDH, la unidad retoma sus investigaciones, esta vez enfocándose sobre la resistencia a los antibióticos y, también sobre la caracterización molecular de patógenos en cuerpos de agua naturales. En el año 2017, también con financiamiento IDH, se emprende en el área de la detección molecular de patógenos virales respiratorios en poblaciones pediátricas.
Posteriormente con el apoyo del grupo del departamento de Microbiología (MTC) del Karolinska Institutet de Suecia y financiamiento Swedish Reseach Links y Swedish Research Council, se amplían las investigaciones del efecto de distintos contaminantes y su relación con las características genéticas, principalmente resistencia a antibióticos, y diversidad de las comunidades microbianas que habitan ecosistemas acuáticos de la región del Altiplano, así como la caracterización fenotípica y molecular de diferentes patógenos en el ambiente. A través de estos proyectos, la unidad ha participado en la formación de recursos humanos a nivel de licenciatura y maestría en la carrera de Biología y su maestría terminal.
Biotecnología ambiental. Los trabajos de Investigación de la Unidad de Biotecnología Ambiental se empezaron a desarrollar a partir del año 2008, en un laboratorio prestado por la Carrera de Biología. Los primeros trabajos estuvieron relacionados con el uso de cepas fúngicas para la degradación de colorantes, tomando en cuenta que las moléculas utilizadas para tintes pueden ser altamente contaminantes y tóxicas. A partir de estos primeros trabajos se produjo una tesis de licenciatura y dos publicaciones científicas, en Biofarbo y en Ecotoxicology and Environmental Safety. La investigación se realizó con material casero y reactivos y equipos prestados. Se realizaron también trabajos sobre el uso de hongos para la producción de celulasas, enzimas que tienen un potencial biotecnológico, por ejemplo, para la producción de biocombustible a partir de residuos agrícolas. En este tema se produjo una tesis de licenciatura.
En 2009, se obtuvo un financiamiento de la Fundación PIEB para el proyecto “Producción in situ de biofertilizantes para la quinua”. Este primer financiamiento permitió dotar al laboratorio de algunos equipos básicos, material y reactivos, y marcó el inicio del trabajo con bacterias fijadoras de nitrógeno para la producción de biofertilizantes. Como resultado de este financiamiento, se ha realizado una publicación patrocinada por PIEB, se ha presentado un trabajo al III Congreso de la Quinua, se ha redactado un capítulo del libro “La UMSA y la quinua” y se ha incluido tesis de licenciatura en Biología y otra en Agronomía. La investigación sobre biofertilizantes y sobre los agroecosistemas donde se produce la quinua se amplió gracias a dos financiamientos adicionales, uno IDH para el proyecto “Uso de biofertilizantes como parte de una estrategia de reforestación y manejo de cultivos en la zona de San José Bajo (Municipio Papel Pampa, La Paz).” (2012-2014) y uno ASDI “Establecimiento inicial de sistemas agroforestales en el Municipio de Papel Pampa (La Paz)” (2014-2016). Estos financiamientos permitieron un mayor equipamiento del laboratorio, así como la realización de tres tesis de licenciatura en Biología y una de Agronomía. Actualmente, se realiza investigación sobre el efecto que tiene la inoculación de bacterias fijadoras de nitrógeno en las comunidades de la rizósfera de la quinua, como parte de un Proyecto SATREPS financiado por LA cooperación japonesa.
Otra línea de investigación que se ha desarrollado en la Unidad corresponde a la degradación de contaminantes orgánicos mediante cepas fúngicas o bacterianas. Esta línea ha podido realizarse gracias a dos financiamientos, uno IDH y otro ASDI (2010-2011). En el caso del proyecto IDH se han aislado cepas fúngicas y bacterianas capaces de degradar plaguicidas piretroides y organofosforados, se ha realizado una tesis de licenciatura. El proyecto ASDI se enfocaba a la degradación de clorofenoles mediante cepas fúngicas y permitió la realización de dos tesis adicionales de licenciatura en Biología. Sobre el tema de degradación de plaguicidas, también se realizó una tesis de maestría por un estudiante de intercambio de la Universidad de Linkoping (Suecia). La experiencia e insumos obtenidos por los mencionados proyectos incluyeron la realización de tres tesis de licenciatura en Biología sobre el tema del uso de reactores MBBR (moving bed biofilm reactor) para fines de bioremediación.
Se ha trabajado en colaboración con la Unidad de Suelos del Instituto de Ecología mediante el programa FIBL, a partir de lo cual se ha realizado una publicación en Agroforestry Systems sobre el efecto de los diferentes sistemas de cultivo de cacao en características microbiológicas y bioquímicas del suelo. Actualmente se mantiene la colaboración. Se ha contribuido al desarrollo de dos tesis de Maestría en Ecología y Conservación, a partir de una de estas tesis se tiene una publicación en Human Ecology.
Biotecnología vegetal. Enfoca sus investigaciones en el uso de técnicas de cultivo de tejidos vegetales para fines de conservación y multiplicación de especies amenazadas y/o endémicas, así como producción de especies de interés, también trabaja sobre transformación y análisis de variabilidad genética de especies vegetales. Asimismo, ha desarrollado trabajos enfocados en el uso de estas técnicas coadyuvando la producción y desarrollo de subproductos vegetales con interés económico y/o farmacéutico. Por otro lado, ha venido trabajando en la identificación y análisis de variabilidad genética de especies vegetales nativas. Finalmente, viene trabajando en el uso de herramientas de secuenciación genómica para identificación de genes o regiones génicas, para apoyar al desarrollo de sistemas de mejoramiento genético de especies vegetales asistido por marcadores moleculares.
En esta Unidad se ha coordinado y participado en investigaciones financiadas por instituciones nacionales e internacionales como Fundación PUMA - Conservación Internacional, Fondo Flamenco para el Bosque Tropical a través de Groenhart vzw, Asociación Armonía, Programa de Biotecnología Vegetal ICGEB-TWAS, Fondos para investigación de IDH-UMSA, Instituto Nacional de Innovación Agropecuaria y Forestal (INIAF), OEA, Global Environment Facility (GEF) y SATREPS (iniciativa entre JICA y JST). A través de los proyectos de investigación se generaron diferentes libros, manuales y cartillas.
Infraestructura
Mediante el financiamiento de fondos IDH entre 2014-2015, el IBMB fue favorecido para iniciar la construcción de cimientos para una nueva edificación en el campus de Cota Cota, acorde con su despliegue y crecimiento. Sin embargo, está a la espera de renovación financiera para proseguir y concluir esa edificación.
Producción intelectual de la Carrera de Biología (Darío Achá)
Fundada en 1830, con sus trece facultades y 55 carreras, la UMSA es una de las universidades más antiguas y la más grande de Bolivia. La importancia internacional, histórica y local de la UMSA viene siendo reconocida en diversos ámbitos, incluidos el de la ciencia. De acuerdo con los datos de Scopus®, entre 2016 y 2017 la Carrera de Biología de la UMSA repuntó con el mayor número de publicaciones científicas internacionales con revisión por pares: entre 68 y 81 publicaciones por año con el 38% y 42%, respectivamente (Achá 2018). Los docentes investigadores de planta generaron 126 artículos y el 61.5% del total ha contribuido con publicaciones internacionales, aunque diez de los docentes no aportó ninguno y son cinco quienes suman el 64% del total (Fig. 1).

Figura 1 Número de publicaciones por docente de la Carrera de Biología de la UMSA entre 1994-2018, registradas en Scopus® (Achá 2018).
Comparado con la información de los últimos cinco años, se muestra que los cinco que más publican aportan el 52% de todas las publicaciones y que se han incrementado en un 76.7% (Fig. 2).

Figura 2 Publicaciones por docente investigador de la Carrera de Biología de la UMSA entre 2018-2022, registradas en Scopus®.
De acuerdo con la base de datos de Scopus®, la UMSA ha contribuido al mes de julio del 2022 con al menos 1.693 artículos en revistas internacionales desde 1950. Esto como resultado del esfuerzo y dedicación de 758 autores, entre docentes, estudiantes e investigadores asociados, nacionales e internacionales. La mayoría de estos artículos (>71.88%) ha sido publicada en los últimos 12 años. Lo que explica que la UMSA aparezca en el ranking de Scimago Institutions Rankings© recién en 2020. Hasta la fecha la UMSA es la única institución boliviana en ese ranking. Sin embargo, lo que es más sorprendente es que la Carrera de Biología sea la responsable de más de 600 de todos los artículos producidos (Fig. 3).

Figura 3 Aporte a la producción científica de la UMSA (a partir de datos de afiliación obtenidos en Scopus®) a. de la Carrera de Biología y b. de otras dos carreras de la FCPN.
El que una sola de las 55 carreras aporte el 36% de la producción científica internacional reportada por Scopus® para toda la UMSA no es solo sorprendente, sino que es un logro indiscutible para la Carrera de Biología. También es un logro indiscutible de la FCPN, ya que Biología junto con las carreras de Física y Ciencias Químicas contribuyen con el 63% del total de las publicaciones internacionales de la UMSA (Fig. 3). Por lo tanto, la Carrera de Biología y la FCPN se constituyen en un pilar fundamental para el impacto global del conocimiento generado por la UMSA y su imagen internacional.
Dentro de la Carrera de Biología existen diferentes unidades que han tenido también una contribución muy dispareja en su aporte. Una idea aproximada podemos obtenerla considerando las menciones a cada una de las unidades en los datos de afiliación de los autores, lo que muestra que los principales contribuidores han mencionado en su afiliación al Instituto de Ecología, la Carrera de Biología y al Herbario Nacional de Bolivia (Fig. 4). Sin embargo, la cantidad de personas que pertenecen o han pertenecido a cada unidad es muy variable, así que quizá no es una comparación perduradera en el tiempo. Quizá más interesante es ver que una gran parte de las contribuciones fue generada en los últimos cinco años, comparadas con casi tres décadas anteriores (Fig. 5). De acuerdo a los registros de Scopus®, Stephan G. Beck (actualmente docente jubilado) fue el primero en publicar un artículo científico internacional y fue afiliado al Herbario Nacional de Bolivia.

Figura 4 Proporción de menciones de la Carrera de Biología, Instituto de Ecología y varias de sus unidades de investigación, así como del Instituto de Biología Molecular y Biotecnología en afiliaciones vinculadas a las publicaciones de la UMSA (basado en datos de Scopus®). El CAE por ejemplo es una unidad que ya no funciona como tal y ha sido incluida en la Unidad de Ecología Terrestre del instituto de Ecología; la CBF y el Herbario son convenios suscritos entre la UMSA y la Academia Nacional de Ciencias.

Figura 5 Número de documentos publicados en revistas internacionales con afiliaciones a la Carrera de Biología, Instituto de Biología Molecular y Biotecnología (IBMB), Instituto de Ecología (IE) y sus unidades Limnología, CAE, Calidad Ambiental (CA), así como los convenios: Colección Boliviana de Fauna (CBF) y Herbario Nacional.
Otro aspecto que respalda esta producción científica son las disposiciones vigentes para auspiciar las investigaciones que realizan estudiantes de pregrado y postgrado en la Carrera de Biología, que se suman a la publicación de artículos en revistas indexadas. En el caso de becarios de proyectos financiados y en convocatorias de becas del Instituto de Ecología, se espera que además de la entrega de las memorias de tesis, los estudiantes preparan artículos científicos en revista relacionadas con el tema de investigación. En el caso de la obtención de grado académico, la estructura de la memoria de tesis sigue a la de un artículo científico; para obtener la maestría en biología, el profesional biólogo entrega la memoria de la tesis y publica al menos un artículo en revista indexada.
Achá, D. 2018. La publicación científica en nuestra Universidad y su impacto nacional e internacional. Ecología en Bolivia 53(2): 77-82.












 uBio
uBio